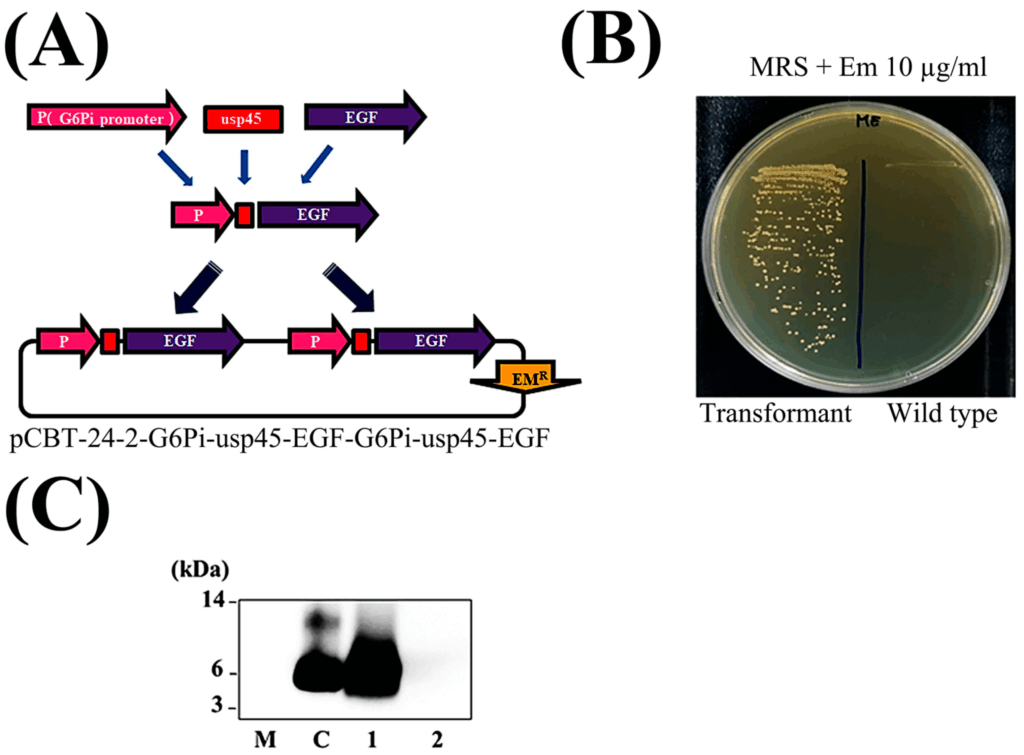

Epidermal Growth Factor (EGF) is a highly promising molecule for the cosmetic industry due to its biological functions, which include promoting cell growth, proliferation, differentiation, and survival, as well as stimulating collagen synthesis and accelerating wound healing processes. These properties make EGF an attractive ingredient for anti-aging and skin repair products. However, traditional recombinant human EGF (rhEGF), often produced using E. coli expression systems, faces significant limitations. These include a costly purification process necessary to remove bacterial endotoxins (lipopolysaccharides or LPS) which can induce pyrogenic responses, its low stability in various environmental conditions (e.g., short half-life), and poor absorption through the skin. Furthermore, the proliferative and anti-apoptotic effects of EGF have raised concerns about potentially enriching genetically damaged cells, although exogenous administration has not been shown to stimulate malignant transformation in wound bed cells.
To overcome these inherent limitations and enhance EGF’s benefits as a cosmetic ingredient, a novel strategy was considered: leveraging genetically modified probiotics. Probiotics are well-known for their safety, wide application range, and ability to produce a diverse array of bioactive molecules such as amino acids, enzymes, vitamins, and immunomodulatory compounds. The cosmetic market for probiotic-derived products is also projected to grow significantly. This approach aims to combine EGF with beneficial probiotic-derived metabolites (postbiotics) to create a safer, more stable, and multi-functional cosmetic ingredient.
Methods
The study involved developing a genetically modified Pediococcus pentosaceus CBT SL4 to secrete human EGF protein into its growth media. The resulting probiotic-derived EGF (PP-EGF) culture medium supernatant (PP-EGF-SUP) was then processed into a dried powder (PP-EGF-DP) using freeze-drying, enhancing its stability and ease of formulation. The researchers subsequently conducted comprehensive in vitro evaluations to assess PP-EGF-SUP’s EGF-mediated bioactivities (cell scratch wound healing, tyrosinase inhibition, anti-wrinkle effects) and probiotic-derived properties (antioxidant, anti-inflammatory, and anti-bacterial activities). Finally, a human application test was performed to determine the efficacy of PP-EGF-DP formulations (1% and 5%) in improving melasma over a four-week period.
Key Findings
• Successful Development of a Probiotic-Derived EGF System: Genetically modified Pediococcus pentosaceus CBT SL4 was successfully developed to secrete EGF protein, resulting in PP-EGF-SUP and its stable dried powder form, PP-EGF-DP. This system offers a significant advantage over E. coli systems by eliminating the need for costly endotoxin purification, as probiotics are inherently safe.
• Potentiation of EGF-Derived Bioactivities:
◦ Enhanced Cell Scratch Wound Healing: PP-EGF-SUP demonstrated wound healing activity similar to or even stronger than that of rhEGF, despite containing significantly lower concentrations of actual EGF protein (e.g., 33-fold lower actual EGF content yet similar recovery).
◦ Superior Tyrosinase Inhibition for Whitening: PP-EGF-SUP showed tyrosinase inhibition efficacy comparable to rhEGF and kojic acid (a positive control) even with 666-fold less EGF protein. This indicates a strong synergistic effect between EGF and probiotic-derived metabolites, contributing to its whitening properties.
◦ Improved Anti-Wrinkle Effects: PP-EGF-SUP significantly increased elastin expression and effectively inhibited collagenase and elastase activities. Notably, its effects were often more potent than those of rhEGF alone, suggesting that probiotic-derived factors play a crucial role in these anti-wrinkle benefits.
• Diverse Probiotic-Derived Bioproperties:
◦ Strong Antioxidant Activity: PP-EGF-SUP exhibited outstanding DPPH inhibition and reactive oxygen species (ROS) scavenging abilities, comparable to positive controls. RhEGF alone did not show significant antioxidant efficacy, indicating that this property originates from the probiotics and complements EGF’s activity.
◦ Anti-Inflammatory Effects: PP-EGF-SUP significantly reduced inflammatory markers, an effect primarily attributed to the probiotics rather than EGF, which showed low efficacy in this regard.
◦ Broad-Spectrum Anti-Bacterial Activity: PP-EGF-SUP demonstrated significant anti-bacterial effects against various harmful skin bacteria, including Propionibacterium acnes (implicated in acne) and Klebsiella pneumoniae. This anti-bacterial activity is a direct benefit from the probiotic’s bioproperties, specifically its secreted postbiotics.
• Enhanced Stability: PP-EGF-DP maintained its biological activity even after the freeze-drying process. It exhibited remarkable thermal stability, retaining approximately 83% of its activity after exposure to 57 °C for one hour, and excellent pH stability, maintaining around 97% of its activity at pH 10 for one hour.
• Proven Efficacy in Human Application Test:
◦ Significant Melasma Improvement: In a four-week human trial, both 1% and 5% PP-EGF-DP ampoules significantly reduced melasma. The 5% formulation led to a 3.79% reduction in light melasma, a 2.93% reduction in dark melasma, and a substantial 29.10% decrease in the overall freckle area. Even the 1% concentration showed considerable improvements (3.38%, 1.74%, and 21.21%, respectively).
◦ High Satisfaction and Safety Profile: 100% of participants reported positive results across various categories, including melasma lightening, skin moisture, and overall satisfaction. No significant adverse skin reactions were observed, affirming its safety.
The novelty of this research lies in its successful integration of a safe probiotic system for EGF production, eliminating costly purification steps, and simultaneously harnessing the multi-functional benefits of probiotic-derived metabolites. This makes PP-EGF-DP a cost-competitive solution for the cosmetic industry. Its future implications are significant, positioning it as a promising, safe, and effective multi-functional cosmetic ingredient for anti-aging, skin repair, and hyperpigmentation treatment, with potential for wider applications in dermatological practice.
The image above illustrates Construction and Detection of EGF in Probiotic System: (A) Engineered plasmid with EGF gene and secretion system. (B) Transformation of Pediococcus pentosaceus SL4 confirmed on agar. (C) EGF protein detected in culture supernatant via Western blotting.
Link to the study: https://www.mdpi.com/2079-9284/12/4/176
